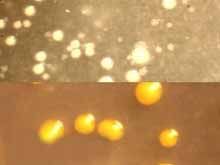
瘰癧分枝桿菌

基本信息
短至長桿菌或絲狀體。在蛋培養基上,37℃培育7天或更長的時間,菌落通常光滑,黃色至橙色。在油酸卵蛋白瓊脂上菌落黃色,光滑。中央圓頂狀,邊緣整齊或不規則。偶有粗糙菌株。生長適溫35℃。分離自兒童頸淋巴腺炎封閉病變。在人分泌物中最常見。見於(特別是兒童的)頸淋巴結膿液,認為是病原菌,也見於人的痰和胃洗液,偶與肺病有關係。偶爾見於土壤;在豬體內發現了這個種的不同血清型。對實驗動物只有有限的致病性,對大鼠、大田鼠、小雞無普遍化的疾病或死亡。偶爾牽連到淋巴結,很少引起肝或脾的局部病變。皮下注射與豚鼠,在注射部位產生膿腫和本區淋巴結膨大;腹腔注射引起本區淋巴結膨大和化膿,總有不同程度的腸膜炎,很少有肝或脾臟的病變,但無普遍化疾病或死亡。盤點世界上的微生物(二)
| 微生物是包括細菌、病毒、真菌以及一些小型的原生動物、顯微藻類等在內的一大類生物群體,它個體微小,卻與人類生活關係密切。涵蓋了有益有害的眾多種類,廣泛涉及健康、食品、醫藥、工農業、環保等諸多領域。 |